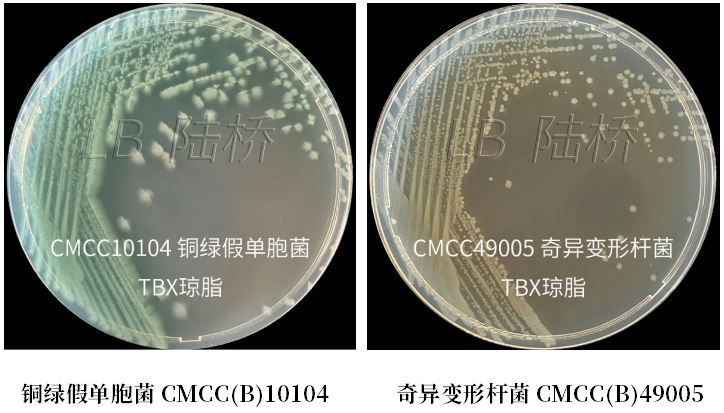
GB 4789.38－2025《食品安全國家標準　食品微生物學檢驗　大腸埃希氏菌計數(shù)》解讀

2025年3月16日頒布的GB 4789.38-2025《食品安全國家標準 食品微生物學檢驗 大腸埃希氏菌計數(shù)》將于9月16日正式實施�����。新標準對范圍、檢驗原理、設備和材料�、培養(yǎng)基和試劑���、檢驗程序、操作步驟�����、結果與報告多個方面都進行了規(guī)定��。由于文本內(nèi)容較多�,我們不再一一贅述?,F(xiàn)將其重大變化總結如下:
重大變化1:MPN法中增加了貝類及產(chǎn)品的接種方法以及MPN表
由于牡蠣等雙殼貝類本身產(chǎn)生β-葡萄糖醛酸苷酶�����,所以更適用于MPN法進行檢測��。在國際標準ISO 16649.3-2015以及FDA BAM中對雙殼貝類產(chǎn)品均采用每個稀釋度接種5管,接種3個連續(xù)稀釋度共15管的方法��。為了滿足出口需要��,新標準中增加了5管接種方法�����,還將需要采用5管接種的范圍擴大為全部貝類及產(chǎn)品。
重大變化2:MPN法中TBX瓊脂取代了EMB及后續(xù)的生化試驗
從MPN法流程來看�,簡化了操作步驟不再進行生化確認��,意味著大大縮短了檢測時間?���?赡艽蠹視幸蓡枺喝∠b定會不會影響結果的準確性呢�����?我們從兩方面進行解答:
1)EMB本身為弱選擇性培養(yǎng)基��,特異性較差����。再加上后續(xù)的生化實驗,操作步驟比較繁瑣�����。
2)TBX是利用大腸埃希氏菌所產(chǎn)生的β-葡萄糖醛酸苷酶�����,與培養(yǎng)基中顯色底物反應�,使菌落著色來區(qū)分大腸埃希氏菌和其他非目標菌��。
標準制修訂專家在標準宣貫時也提到TBX的特異性遠遠高于EMB�����,同時β-葡萄糖醛酸苷酶的準確度也明顯高于生化鑒定IMViC。
重大變化3:平板計數(shù)法中TBX瓊脂取代了VRBA和VRBA-MUG
如果說MPN法中TBX瓊脂的引入提高了時效����,那么平板計數(shù)法又為何用TBX瓊脂來取代同樣無需生化確認的VRBA-MUG呢�����?我們要從VRBA-MUG的反應原理說起,VRBA-MUG同樣是利用大腸埃希氏菌所產(chǎn)生的β-葡萄糖醛酸苷酶����,不同的是培養(yǎng)基中的底物為4-甲基傘形酮-β-D-葡萄糖苷(MUG)��。大腸埃希氏菌能夠分解培養(yǎng)基中的MUG,使4-甲基傘形酮游離出來��,在長波紫外光下產(chǎn)生藍色熒光��。因為菌落計數(shù)依賴于熒光的觀察,所以實際操作時可能會遇到一些問題���。
1)紫外燈:觀察熒光需要合適的紫外燈,不同紫外燈下觀察到的熒光有明顯差異。所以配置時需要關注波長���、功率等。

兩臺不同紫外燈觀察到的熒光強弱有差異
2)計數(shù):4-甲基傘形酮具有水溶性,即使在標準規(guī)定的適宜菌落數(shù)的平板上�����,熒光擴散很容易將非目標菌也染上熒光�,造成計數(shù)困難。

不同目標菌數(shù)量時顯現(xiàn)的熒光情況
3)假陰性:2012版標準接種方式為先傾注VRBA再覆蓋VRBA-MUG,不能直接接觸到VRBA-MUG的目標菌熒光不明顯,可能導致假陰性��。

4)試驗器皿的干擾:要求材質(zhì)良好且潔凈無殘留�����。因為某些器皿材質(zhì)本身含有熒光物質(zhì)���,或者清洗時殘留的洗滌劑也可能會有熒光��,容易造成假陽性結果。
5)標準菌株對照:操作時要求使用陽性目標菌和陰性菌作為對照��,以保證結果的有效性��。
綜上所述���,VRBA-MUG在實際應用中存在諸多難點�,而TBX瓊脂具有良好的特異性����,單純從菌落顏色來進行判定����,不僅無需配置特定設備��,而且觀察簡單明了,也減少了判讀誤差。
TBX瓊脂是胰蛋白胨膽鹽 X-葡萄糖醛酸苷(TBX)瓊脂的簡稱��,原理是利用大腸埃希氏菌所產(chǎn)生特異性的β-葡萄糖醛酸苷酶���,分解TBX瓊脂中的5-溴-4-氯-3-吲哚-β-D-葡萄糖醛酸苷底物���,形成藍綠色菌落��,從而區(qū)分目標菌和其他菌�。
--注:絕大多數(shù)大腸埃希氏菌具有β-葡萄糖醛酸苷酶活性��。但大腸埃希氏菌 O157等菌株沒有β-葡萄糖醛酸苷酶活性�����。另外,腸桿菌科內(nèi)一些志賀氏菌、沙門氏菌等菌株也具有β-葡萄糖醛酸苷酶活性�。

接著看看分別用標準菌株驗證目標菌回收率����、非目標菌特異性及選擇性����,以及使用樣品添加、質(zhì)控樣品及自然污染樣品驗證其實際應用的結果。
1)標準菌株試驗:不同菌株生長情況如表1所示�。
--大腸埃希氏菌在TBX瓊脂上菌落形態(tài)為藍綠色且菌落中心顏色深���,回收率PR均大于0.7(質(zhì)控依據(jù)參照VRBA瓊脂)���;
--大腸埃希氏菌O157由于不產(chǎn)生β-葡萄糖醛酸苷酶,則表現(xiàn)為無色菌落�;
--多數(shù)非大腸埃希氏菌的腸桿菌科細菌呈現(xiàn)無色菌落��;
--銅綠假單胞菌由于可產(chǎn)生藍綠色素,呈現(xiàn)綠色擴散菌落�����,可以與大腸埃希氏菌進行區(qū)分���;
--沙門氏菌中亞利桑那沙門因具有β-葡萄糖醛酸苷酶的活性會引起誤判����,但沙門作為致病菌更應該被監(jiān)測,所以也算是誤打誤撞可以一網(wǎng)打盡��;
--枯草芽孢桿菌�、金黃色葡萄球菌和單核細胞增生李斯特氏菌等革蘭氏陽性菌株在TBX瓊脂上被完全抑制。
表1:不同標準菌株在TBX瓊脂上生長情況

2)模擬實際應用:
將TBX瓊脂應用于樣品(含陽性添加)及質(zhì)控樣品的檢測�,使用平板計數(shù)法進行試驗���,大腸埃希氏菌均呈現(xiàn)出鮮明的藍綠色���,與非目標菌容易區(qū)分�,觀察計數(shù)非常輕松�����。而高污染背景的下水道涂抹(直接劃線)和廁所水樣品(平板計數(shù)法)用TBX瓊脂檢測時����,也能呈現(xiàn)出很好的選擇性����。


因此,TBX瓊脂無論是標準菌株試驗還是模擬實際應用���,不僅操作簡單����、計數(shù)簡便�����,其生長率、特異性和選擇性都呈現(xiàn)很好的效果��。